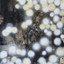
Bright light

Songs by Feeldog
1 tracksFrequently Asked Questions
Songs from artists are not automatically loaded to optimize our database. To add a missing song, simply search for it on our homepage using the song's link or name. It may take a few hours for the song to appear on this page due to caching.
Songs often have multiple releases with different artwork. We typically display artwork from the earliest release based on the ISRC (International Standard Recording Code). If you notice an error, please contact us with the Spotify ID and we'll manually update it.
Search for each song individually on our homepage. Once searched, we'll start tracking it daily and it will appear on this artist page.
About Feeldog
Track Spotify streaming data for Feeldog on MyStreamCount. We are currently monitoring 1 tracks from this artist, providing daily stream count updates and historical data charts. Get insights into streaming trends and watch how their music performs over time.